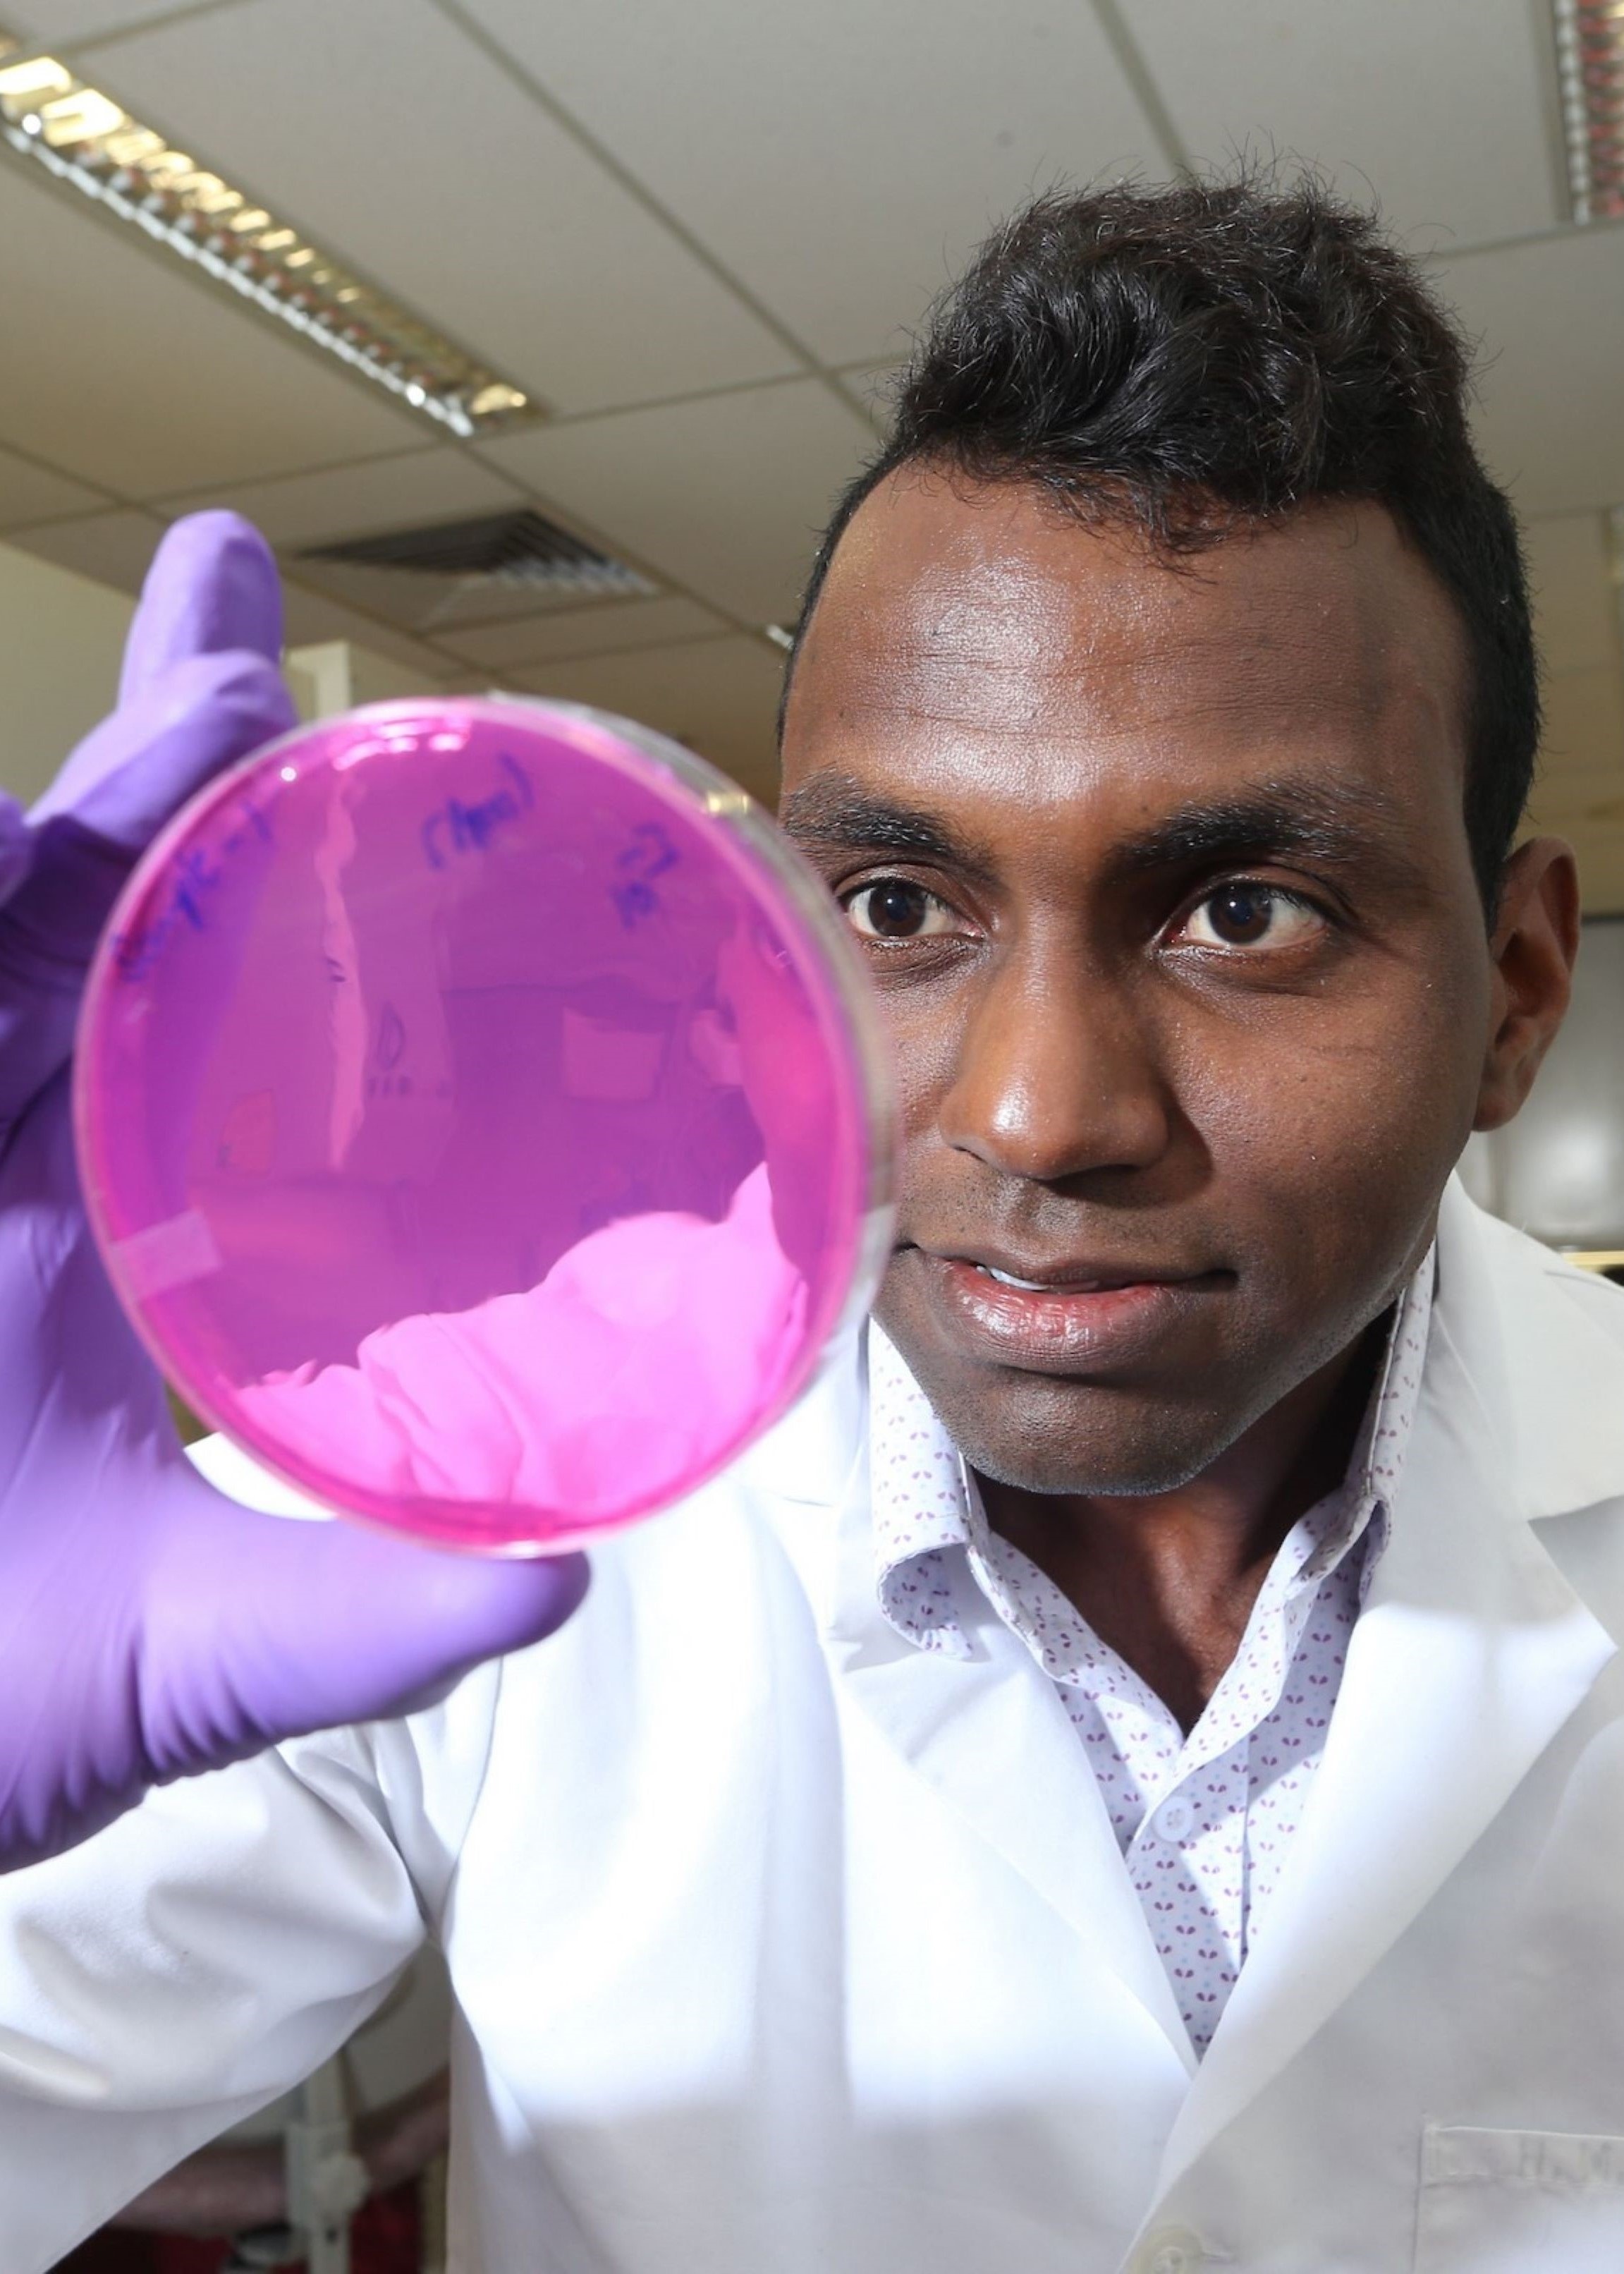

Purdue Food Science Online Academy
ADVANCE YOUR CAREER ON YOUR TERMS
The global food industry is evolving rapidly, creating a high demand for skilled professionals in food safety, quality assurance, and product innovation.
With flexible, 100% online courses, you’ll gain practical, industry-relevant skills from renowned Purdue faculty while earning recognized professional certificates that can be applied immediately to your career.
Purdue Food Science Online Academy
Program offerings

Admissions
Purdue Food Science Online Academy programs provide technical training for industry professionals. To set students up for the greatest success, there are prerequisite courses that are strongly recommended before enrolling in our programs.Cost varies per certificate
- Visit individual registration pages for current pricing
- *Discounts available
- Contact us for tuition details & employer reimbursement options
- Bachelor’s Degree (BS) or Equivalent Experience*
- *Science-related field preferred.
- Completed 15 credit hours of science based coursework
- Recommended courses: Biology, Microbiology, Physics, Chemistry, Organic Chemistry, Calculus (lab courses preferred)
Cost varies per certificate
- Visit individual registration pages for current pricing
- *Discounts available
- Contact us for tuition details & employer reimbursement options
- Bachelor’s Degree (BS) or Equivalent Experience*
- *Science-related field preferred.
- Completed 15 credit hours of science based coursework
- Recommended courses: Biology, Microbiology, Physics, Chemistry, Organic Chemistry, Calculus (lab courses preferred)
Enhance your educational benefits. Develop your workforce strategy. Find our courses in Guild.
Learn moreEnhance your educational benefits. Develop your workforce strategy. Find our courses in Guild.
Learn moreFrequently Asked Questions
Our programs go beyond standalone certificates, offering comprehensive training developed by leading Purdue faculty and industry experts.
Working professionals, career changers, scientists, engineers, and anyone looking to specialize in food science.
Yes! Contact us for a sample course preview and insights into the learning experience.
Purdue’s online courses are designed for engagement and real-world application. Check out Purdue Online or online learning success tips.
Did you know that you can use your Veterans Affairs GI Bill benefits for our certificates?
No need to self-enroll. If you are a qualifying veteran or eligible dependant, send us an email with your intent to use GI Bill benefits and what course you're interested in. We are happy to facilitate your verification and enrollment. Thank you for your service.
Food Science Online Academy Team

Hanyu Chen Chen Ph.D.

Connect with us
Interested in leveling up your career, but not sure where to start? Here are some ideas for your first step toward your next giant leap:
- Contact us at FoodSciOnline@purdue.edu so we can set up a meeting and figure out what certificate fits your needs.
- Talk to your employer about our corporate package discounts available to train you and your coworkers.
- Follow us on LinkedIn and Instagram for the latest discounts and program updates.

